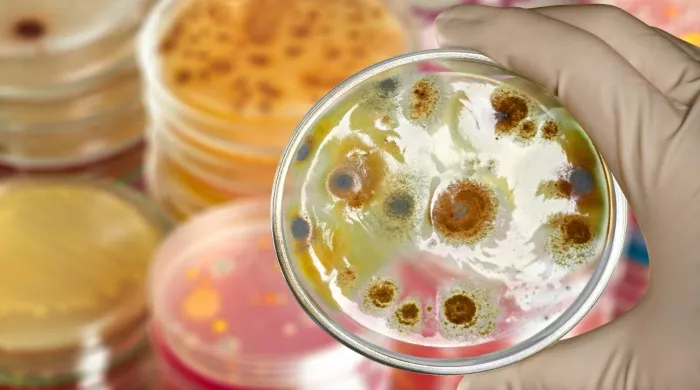
trovanje hranom

TOKSIČNA REAKCIJA
Trovanje hranom uzrokovano stafilokoknim toksinima karakteriše kratak inkubacijski period, do osam sati, snažna mučnina, povraćanje i proliv, bez pojave povišene telesne temperature.
Staphylococcus aureus je bakterija koja u određenim okolnostima može izazvati bolest.
Staphylococcus aureus je bakterija koja kod zdravih ljudi najčešće naseljava kožu i sluzokožu nosa. Ova bakterija u određenim okolnostima može izazvati bolest. Između ostalog, Staphylococcus aureus stvara toksine koji mogu prouzrokovati trovanje hranom.
Kontaminacija hrane stafilokokom i toksinima nastaje tokom skladištenja, prerade, pripreme ili distribucije. Najčešće se dešava preko ruku osoba koje pripremaju hranu i preko pribora za pripremu hrane, kao što su noževi, daske za sečenje mesa, posude u kojim se čuva hrana.
Uslovi koji pogoduju produkciji toksina u hrani koja je kontaminirana stafilokokom:
– nadekvatno čuvanje hrane posle pripreme
– priprema hrane mnogo pre konzumiranja
– nedovoljno kuvana ili zagrejana hrana
– prolongirano zagrevanje na grejnim pločama kod serviranja hrane.
Stafilokokna trovanja se mogu javiti sporadično, u kućnim uslovima, i epidemijski, nakon konzumiranja hrane u ugostiteljskim objektima, navodi se na sajtu Gradskog zavoda za javno zdravlje.
Epidemije su najčešće leti, kada su visoke temperature i hrana se ne čuva na odgovarajući način. Najrizičnija hrana su mleveno meso, puding, sladoled, sendviči.
Trovanje hranom uzrokovano stafilokoknim toksinima karakteriše kratak inkubacijski period, do osam sati, snažna mučnina, povraćanje i proliv, bez pojave povišene telesne temperature.
Bolest je je uglavnom blaga, a oporavak nastupa kroz jedan do tri dana. Lečenje se sastoji u nadoknadi tečnosti, lekovima protiv grčeva u stomaku i mirovanju.
Preventiva
– osobe koje rukuju hranom pri pripremanju i distribuciji (kuvari,konobari ) moraju se pridržavati opštih higijenskih mera radi sprečavanja kontaminacije hrane
– detaljno pranje ruku, posebno ispod i oko noktiju, sapunom i tekućom vodom pre započinjanja rada sa hranom
– ne učestvovati u pripremii hrane ukoliko imate ranice ili infekcije kože na rukama
– radne površine i pribor za pripremu hrane održavajte čistim
– ukoliko se hrana neće potrošiti za vreme od dva sata od pripreme, čuvajte je na temperaturi iznad 60 stepeni Celzijusa ili ispod pet stepeni Celzijusa.